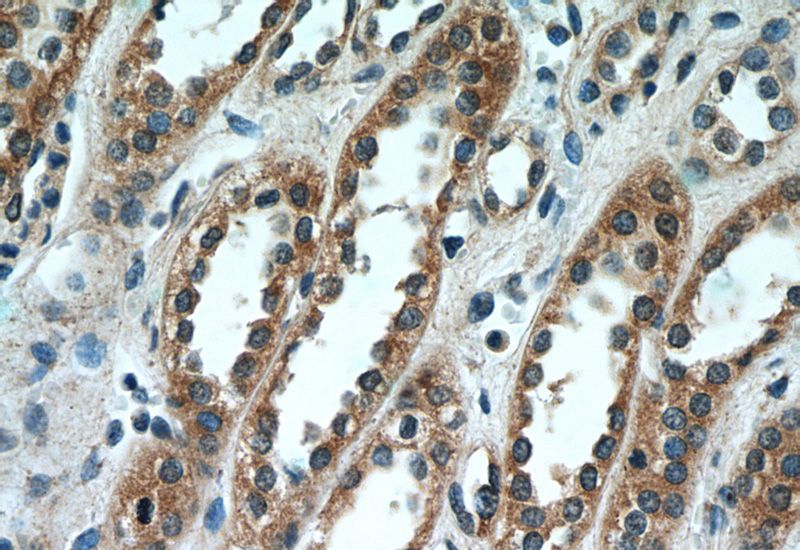
Immunohistochemistry of paraffin-embedded human kidney tissue slide using Catalog No:115010(SCNN1A Antibody) at dilution of 1:50 (under 40x lens)

-
Product Name
SCNN1A antibody
- Documents
-
Description
SCNN1A Rabbit Polyclonal antibody. Positive IHC detected in human kidney tissue. Positive WB detected in human brain tissue. Observed molecular weight by Western-blot: 60 kDa, 83 kDa
-
Tested applications
ELISA, WB, IHC
-
Species reactivity
Human,Mouse,Rat; other species not tested.
-
Alternative names
Alpha ENaC antibody; Alpha NaCH antibody; ENaCa antibody; ENaCalpha antibody; FLJ21883 antibody; SCNEA antibody; SCNN1 antibody; SCNN1A antibody
-
Isotype
Rabbit IgG
-
Preparation
This antibody was obtained by immunization of SCNN1A recombinant protein (Accession Number: BC006526). Purification method: Antigen affinity purified.
-
Clonality
Polyclonal
-
Formulation
PBS with 0.1% sodium azide and 50% glycerol pH 7.3.
-
Storage instructions
Store at -20℃. DO NOT ALIQUOT
-
Applications
Recommended Dilution:
WB: 1:200-1:2000
IHC: 1:20-1:200
-
Validations

human brain tissue were subjected to SDS PAGE followed by western blot with Catalog No:115010(SCNN1A antibody) at dilution of 1:500

Immunohistochemistry of paraffin-embedded human kidney tissue slide using Catalog No:115010(SCNN1A Antibody) at dilution of 1:50 (under 10x lens)
Immunohistochemistry of paraffin-embedded human kidney tissue slide using Catalog No:115010(SCNN1A Antibody) at dilution of 1:50 (under 40x lens)
-
Background
SCNN1A (sodium channel, non-voltage-gated 1 alpha), also known as ENaCA (epithelial Na(+) channel subunit alpha) or amiloride-sensitive sodium channel subunit alpha, is the alpha subunit of the epithelial Na(+) channel (ENaC). ENaC is expressed in the apical membrane of salt-absorbing epithelia of kidney, distal colon, and lung. ENaC is a non-voltage gated, constitutively active channel highly selective for sodium. It has an essential role in salt and fluid homeostasis across epithelial tissues. ENaC consists of three different subunits: alpha, beta, gamma. Mutations in the gene of SCNN1A have been associated with pseudohypoaldosteronism type 1 (PHA1), a rare salt wasting disease resulting from target organ unresponsiveness to mineralocorticoids.
-
References
- Yang Y, He G, Xu W, Liu X. ENaC mediates human extravillous trophblast cell line (HTR8/SVneo) invasion by regulating levels of matrix metalloproteinase 2 (MMP2). Placenta. 36(5):587-93. 2015.
- Wang S, He G, Yang Y. Reduced expression of Enac in Placenta tissues of patients with severe preeclampsia is related to compromised trophoblastic cell migration and invasion during pregnancy. PloS one. 8(8):e72153. 2013.
- Roll JD, Rivenbark AG, Sandhu R. Dysregulation of the epigenome in triple-negative breast cancers: basal-like and claudin-low breast cancers express aberrant DNA hypermethylation. Experimental and molecular pathology. 95(3):276-87. 2013.
- Zhou M, Fu J, Huang W. Increased cystic fibrosis transmembrane conductance regulators expression and decreased epithelial sodium channel alpha subunits expression in early abortion: findings from a mouse model and clinical cases of abortion. PloS one. 9(6):e99521. 2014.
Related Products / Services
Please note: All products are "FOR RESEARCH USE ONLY AND ARE NOT INTENDED FOR DIAGNOSTIC OR THERAPEUTIC USE"
